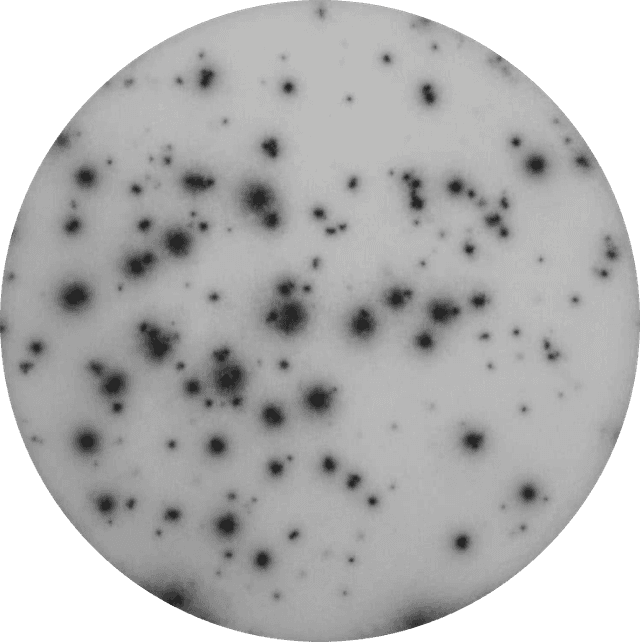

Peptide pools that spark immune insight
ELISpot and FluoroSpot assays require stimuli to detect antigen-specific immune responses. For this reason, we have developed high-quality and optimized peptide pools, called PepPools, that can be used for specific research purposes. PepPools are particularly useful for researchers who work with a pathogen but do not have access to or knowledge of suitable antigens. All our PepPools have been validated for ELISpot and FluoroSpot in individuals who have had the infection or have been vaccinated.
Our portfolio offers a range of defined peptide pools for specific HLA/MHC molecules, as well as scanning pools that cover the entire protein or specific domains. For HLA coverage of the different pools, please refer to each product's page.
Pathogen-specific pools
PepPools are particularly valuable for researchers working with a given pathogen who may lack access to, or detailed knowledge of, suitable antigens. In addition, all PepPools are validated for use in ELISpot and FluoroSpot assays and tested in individuals with confirmed exposure to the relevant infection, providing confidence in their performance and relevance.
Positive control pools
Proper positive controls are essential for reliable performance in immunoassays. For many years, peptide pools composed of well-characterized antigens known to elicit T-cell responses have been widely used as antigen-specific positive controls.
Depending on cohort, it may be extremely important to use antigen-specific positive controls that are effective across a broad range of populations with diverse genetic and ethnic backgrounds. Our CEF- CEFTA- and CEFRAS PepPools are optimized for such challenges.
Explore more?